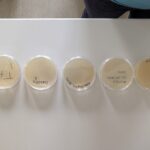

Passend zu unserem Lehrstoff zur Immunbiologie hörte die 6A am 13. Oktober einen überaus interessanten Vortrag zu pathogenen Bakterien von PhD Fiona Hager-Mair, die im Rahmen der Initiative Wissenschafft Zukunft der BOKU Wien unsere Schule besuchte.
Passend zu unserem Lehrstoff zur Immunbiologie hörte die 6A am 13. Oktober einen überaus interessanten Vortrag zu pathogenen Bakterien von PhD Fiona Hager-Mair, die im Rahmen der Initiative Wissenschafft Zukunft der BOKU Wien unsere Schule besuchte.
Neben recht anspruchsvoller Theorie zu den Strategien der Bakterien, sich vor unserem Immunsystem zu verstecken, brachte uns unsere Vortragende auch Agarplatten mit, die sogleich mit Fingerabdrücken unserer SchülerInnen versehen wurden. Mal sehen, wofür wir hier einen Nährboden haben – wir werden berichten.